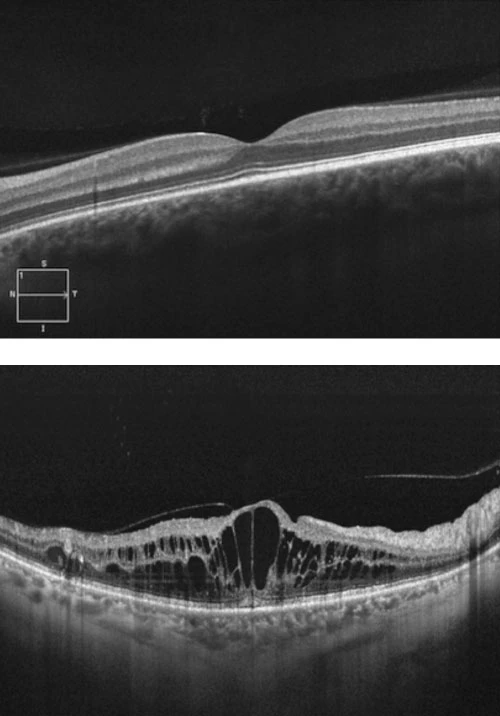
Ocular Coherence Tomogram (OCT)

Branch retinal vein occlusion (BRVO)
Branch retinal vein occlusion (BRVO) is a vascular occlusive disease of the retina, caused by thrombotic occlusion of a retinal venule where it is crossed by an arteriole.
Systemic hypertension is by far the most common risk factor, resulting in arteriosclerosis and secondary compression of an underlying venule where these cross in the retina. Young patients or those with bilateral or recurrent BRVOs additionally require investigation for thrombophilia, vasculitis, and connective tissue diseases.
Patients present with a sudden, painless visual field defect corresponding to the affected area of the retina. They may also present with insidious blurring of central vision due to macular oedema. If the branch retinal vein occlusion is in the peripheral retina, patients may have no symptoms until they develop secondary complications.
Branch retinal vein occlusion results in venous stasis, and if significant, can cause secondary retinal ischaemia. This can in turn result in neovascular complications such as glaucoma, vitreous haemorrhage and retinal traction. In addition, BRVO is often associated with macular oedema, which causes vision loss. The presence and extent of macular oedema can be measures by an ocular coherence tomogram (OCT), which is a useful tool for documenting the response to treatment.
Ocular Coherence Tomogram (OCT)
Prior to the advent of intravitreal anti-VEGF agents, retinal photocoagulation (laser) was the mainstay of treatment of BRVO with underwhelming results for recovery of vision. Ranibizumab (Lucentis™) which is an anti-vascular endothelial growth factor A (VEGF-A) monoclonal antibody fragment has largely superseded laser for management of macular oedema due to BRVO. Lucentis™ is delivered into the eye by intravitreal injection, with most patients requiring a course of treatment, which begins monthly, and is subsequently extended according to response. Response to treatment is measured by improvement of vision and resolution of macular oedema on OCT.
Branch retinal vein occlusion is not an ocular emergency, and therefore referral to an ophthalmologist within 1-2 weeks is sufficient, as long as the diagnosis has been confirmed. If the patient is on anticoagulants, these do not need to be ceased. Patients often have other vascular risk factors, which increased their chance of developing ischaemic heart disease and stroke, and general practitioners are best placed to help manage these conditions to improve the patients’ overall health outcomes.


